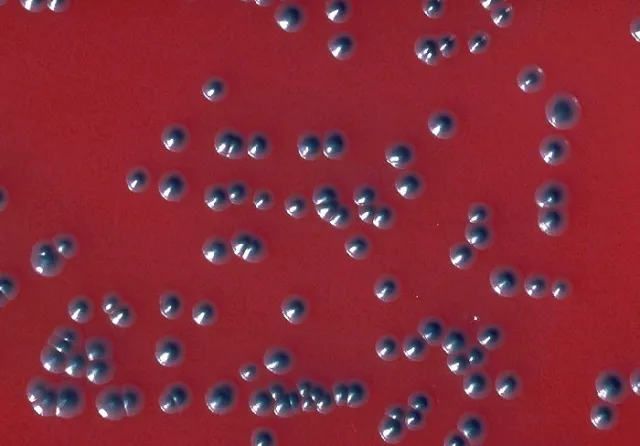
Colonies of Corynebacterium diphtheriae biotype gravis in tellurite blood agar - Colonies ofCorynebacterium diphtheriaebiotype gravis in tellurite blood agar(Image source:CDC/ Dr. W.A. Clark )

Corynebacterium diphtheriae also known as Klebs-Löffler bacillus is a Gram-positive bacillus responsible for causing diphtheria. Once a major cause of illness and death among children, diphtheria became a rare disease after the administration of vaccination.

The genus and species names are derived from the Greek word: korynee (“club”) after the microscopic appearance of the organisms and diphtheria (“leather hide”) for the pseudomembranethat is the hallmark of respiratory tract infection.
General properties
- Gram-positive rods, that are club-shaped due to the presence of metachromatic (volutin) granules at one or both ends. Cells are arranged singly, in “palisades” of parallel cells, or in pairs that remain connected after cell division to form V, or L shapes (Chinese letters appearance).
- Nonmotile, non-capsulated, and non-sporing.
- Aerobes or facultative anaerobes,
- Fastidious organisms; grows best at 37 °C on blood or serum-containing media such as Loeffler’s medium, tellurite medium, etc.
- Ferment glucose, starch glycogen.
- Catalase positive, non-pigmented, oxidase negative, indole negative, and do not form phosphatase.

Pathogenesis ofCorynebacterium diphtheriae
Disease Transmission
The source of infection is carriers who harbor the organisms in the oropharynx or skin. Human to human transmission is spread by respiratory droplets, secretions, or direct contact with infected cutaneous lesions.
Corynebacterium diphtheriaeis not the part of the normal flora of humans but coryneforms bacteria are normal flora and may mistaken forC. diphtheriaein gram staining)
C. diphtheriae is not an invasive organism. The pathogenesis of diphtheria is based on its potent exotoxin carried by lysogenized strains of C. diphtheriae.
Mode of action of Diphtheria toxin

Like other exotoxins (botulinum, tetanus, cholera toxin), diphtheria toxin also has A and B subunits. The A or active subunit possesses the toxic activity, and the B or binding subunit is responsible or binding the exotoxin to specific receptors.
The toxin binds to the cell surface via its binding subunit (B), and the active subunit (A) enters the cell. The active subunit is an enzyme that catalyzes the addition of ADP-ribose (ADP-R) to elongation factor-2 (EF-2). This inactivates EF-2, and protein synthesis is inhibited, leading to the death of host cells.
In addition toC. diphtheriae, two other corynebacteria species can produce diphtheria toxin and thus also cause diphtheria:C. ulceransand very rarelyC. pseudotuberculosis.
Clinical manifestations
There are two types of clinical diphtheria: nasopharyngeal (respiratory) and cutaneous.
Respiratory diphtheria

Fever, sore throat, and cervical adenopathy are early and non-specific signs of respiratory diphtheria. Formation of the thick, gray, adherent pseudomembrane over the tonsils and throat is the most prominent specific sign. If not treated early, the extension of pseudomembrane may lead to laryngeal obstruction, asphyxia, and death. Complications of diphtheria include myocarditis, cranial nerve weakness, and peripheral neuritis.
Cutaneous diphtheria
Cutaneous diphtheria occurs by skin contact with other infected persons and appears as ulcerating skin lesions covered by a gray membrane. These lesions do not invade surrounding tissues and the systemic symptoms rarely occur.
Laboratory Diagnosis of Diphtheria
Laboratory diagnosis of Corynebacterium diphtheriae involves isolation of the organism and subsequent demonstration of toxin production.
Sample: Swabs (preferably two) from the lesion of throat, larynx or nasal cavity; one for direct examination and another for culture or a portion of the pseudomembrane.
Direct examination

Smears of the throat swab should be stained with both Gram stain and methylene blue or Albert stain. Appearance of many tapered, irregularly stained, pleomorphic (typically arranged in Chinese letter or cuneiform arrangements) gram-positive rods is suggestive of Corynebacterium diptheriae. Typical metachromatic granules are seen in methylene blue stain or in Albert stain. C. diphtheriaeappears as green bacilli with bluish-black metachromatic granules in Albert stain.
Culture
Corynebacterium diphtheriae is a fastidious organism, so it does not grow on the ordinary medium. To avoid the growth of commensals and to differentiate among various biotypes, the sample should be culturedon a selective and differential medium such as cystine-tellurite blood agar and modified Tinsdale’s medium.
In addition, Loeffler’s medium, containing serum and eggs, stimulates the growth of C. diphtheriae and stimulates the production of metachromatic granules within the cells. Primary plating in Loeffler’s medium is not recommended due to the growth of commensals.
Blood tellurite agar: It is a selective and differential medium forC. diphtheriae. After 48-72 hours, colonies of C. diphtheriae appear as small, grey, or black with a raised center. Biotypes (gravis, intermedius, mitis, and belfanti) can be differentiated on the basis of colony morphology on tellurite blood agar and biochemical tests such as;
- Urease
- Nitrate reduction
- Esculin hydrolysis
- Fermentation of Glycogen
- Lipophilic characteristics

Tinsdale’s Agar: After incubation for at least 48 hours, colonies of Corynebacterium diphtheriae appear black with dark brown halos.
Rapid identification methods
API Coryne strip and RapID CB Plus are commercial products available for the rapid identification of Corynebacterium diphtheriae.
Virulence test
Definitive identification of C. diphtheriae isolates as a true pathogen requires a demonstration of toxin production. The toxigenicity of C. diphtheriae strains is determined by a variety of in vitro and in vivo tests:
- Elek immunodiffusion test: It is the most common in vitro assay for determining toxigenicity of C. diphtheriae. This test is based on the double diffusion of diphtheria toxin and antitoxin in an agar medium. A sterile, antitoxin-saturated filter paper strip is embedded in the culture medium, and C diphtheriae isolates are streak-inoculated at a 90° angle to the filter paper. The production of diphtheria toxin can be detected within 18 to 48 hours by the formation of a toxin-antitoxin precipitin band in the agar.
- Detection of toxin gene by polymerase chain reaction (PCR).
- Guinea pig lethality test
Treatment and immunization
Treatment is achieved by suppression of bacterial growth by administration of penicillin and erythromycin antibiotics that eliminates C. diphtheriaeand terminate the production of toxin.
One attack of diphtheria provides lifelong immunity.
Active immunization is achieved by the administration of diphtheria toxoid: formaldehyde inactivated diphtheria toxin. In endemic areas vaccine is started at 3 months and 3 doses are given at 6-8 weeks interval and a booster dose at 6 years. It is often administered in combination with tetanus, and pertussis vaccine.
Passive immunization is considered an emergency measure when a susceptible person is exposed to infections and in such case 500-100units of antitoxin is administered subcutaneously after a skin test (Schick test).
References and further readings
- Tille, P. (2017). Bailey & Scott’s Diagnostic Microbiology (14 edition). Mosby.
- Procop, G. W., & Koneman, E. W. (2016). Koneman’s Color Atlas and Textbook of Diagnostic Microbiology(Seventh, International edition). Lippincott Williams and Wilkins.
- Jamal, S. B., Tiwari, S., Silva, A., Azevedo, V., Jamal, S. B., Tiwari, S., Silva, A., & Azevedo, V. (2017). Pathogenesis ofCorynebacterium diphtheriaeand available vaccines: An Overview. Global Journal of Infectious Diseases and Clinical Research, 3(1), 020–024.